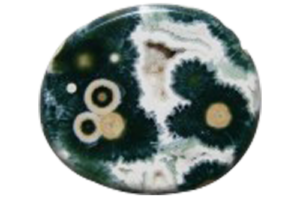
Beautiful jasper gemstone

Edge painting
Each book has its own unique appearance, but the surest way to give it an out-of-the-ordinary look is to make its outer edges different from those of other books – either by colouring, by gilding, or with a pattern. To do this, the process of finishing your book must end with edge painting.
In the following we will see what edge painting is, where it comes from, what its current status is, and in particular how Pulsio Print can help you embellish your books by applying this technique.
What is edge painting?
Today we call “edge painting” all the activities related to the embellishment of the paper edges of a book.
According to the ‘Methodical Encyclopaedia’, published towards the end of the 18th century:
“The embellishments of the book edges consist of a red colour or a marbled effect, or often gilding; sometimes even small drawings of random figures are made, in what is called ‘aging the edges.”
In the book ‘The Art and Practice of Bookbinding’, which came out in 1898 (and whose most recent reprint was in 2016!), there is this about book edge ornamentation:
“Preparing the edges – This is the name for the operations by which the edges of a volume are given either a plain colour, a patterned or a marbled effect, or a layer of gold or silver.”

The origins of the name “Edge painting”
The word “edge painting” means work that consists of making patterns, imitations of marble effects on lacquered wall panels or on metal, on the edges of a book. In Volume 4 of another important work, ‘Necessary Knowledge for a Bibliophile’, we discover that at the end of the 17th century, and throughout the 18th, edge painting was also used on leather intended for bookbinding.
Marble is a metamorphic rock that can have several appearances: speckled, banded, red (or oriental), red spots on a green background, black (from Sicily), etc.
Of sedimentary or volcanic origin, it is therefore a transformational substance, sometimes classified as a mineral, sometimes as rock, depending on or its levels of impurities. Its most important characteristic, besides its widespread occurrence, is its wide range of natural colours.
No colour is impossible for marble, which allows us to give its name to all kinds of different surfaces with varied patterns and hues.

Old edge painting applications
Volume VIII of ‘Descriptions of Arts and Crafts’, which came out in 1777, gives techniques for the application of all manners of embellishment for book edges.
The Methodical Encyclopaedia teaches us that “our old books of the sixteenth century […] almost all, are aged at the edges”. Aging the edges is done “if you want to push individuality and magnificence as far as possible”.
The aesthetics of the time imposed ornamentation of book edges as an integral part of the appearance of a book. Its importance was such that according to ‘The Art and Practice of Bookbinding’:
“There are usually special workers who can pattern, marble or gild, but it is useful for a bookbinder to know about the processes that are used, so that they can achieve the same results, if necessary, without the help of specialists, especially if they live in a small town.”
And while the ‘Methodical Encyclopaedia’ spoke about a red colour applied to book edges, a hundred years later ‘The Art and Practice of Bookbinding’ described all the colours available and gave in minute detail methods for ink preparation both for uniform colour and for marbling.
The demand was there, and so new techniques developed. Edge painting became almost a fashion trend, with in-house models kept by the major printing companies of the time. ‘The Art and Practice of Bookbinding’ gives us an idea of some of the models of printing house A. Scherf, 19, rue Saint-Séverin, Paris.



But preparing the edges (our edge painting today) doesn’t just serve to embellish a book. The practical usefulness of this process should not be neglected. According to the author of the article about it in the Encyclopaedia already quoted:
“Although these colours and ornaments seem merely to add charm, and it seems that they do not add any merit or real advantage to a book, I do not think they are completely useless, since they prevent the pages from wearing out as quickly as they might, and prevent marks from appearing as visibly as if the edge remained in the original colour of the paper; at least this seems so certain to me that certain books that are used a lot, such as, for example, church books, stay clean longer when they are gilded on the edges than when they are simply reddened or marbled, as is the normal practice for books sold by booksellers.”
So, in an age when print runs were limited and books passed from hand to hand, edge painting was also used to ensure their longevity.
Edge painting today
Today, edge painting has lost its role of protector. But the passage of time has meant that, contrary to the opinion of Methodical Encyclopaedia, it can add real benefit to a book. A book with edge painting stands out from a distance. It attracts attention. At first, it’s the edge painting’s individuality that catches the eye, but then on reflection we see that the printer did something more for this book besides printing and binding, and this effort deserves our attention.
We are no longer in the era of ‘The Art and Practice of Bookbinding’; most printing and binding processes are now industrialised. Edge painting is no exception, and this sometimes allows us to add edge painting to large print runs. But the quality work that impresses most and adds maximum value to a book is always done by hand.
Often the films (or foils) for metallic marbling (gilding the edges) come from the same suppliers as those intended for hot stamping. The world market leader is undoubtedly the German company Kurtz. To colour the edges, we use aerosols or special stamps.
Pulsio Print and edge painting
Armed with its long experience, Pulsio Print is able to bring to fruition all your ideas for embellishing the edges of your books.
Put them in a class of their own with gold or a solid colour:




Give them extra style by replicating one of the colours of the cover on the edge:


Or create something fun with vivid colours that correspond to the content of the book:


If you have other ideas and wishes for edge painting, other designs or artistic creations, do not hesitate to contact us. Together we will study them and find ways to implement them so that your books become remarkable and unique.
Check our price: it’s free and it only takes seconds!



